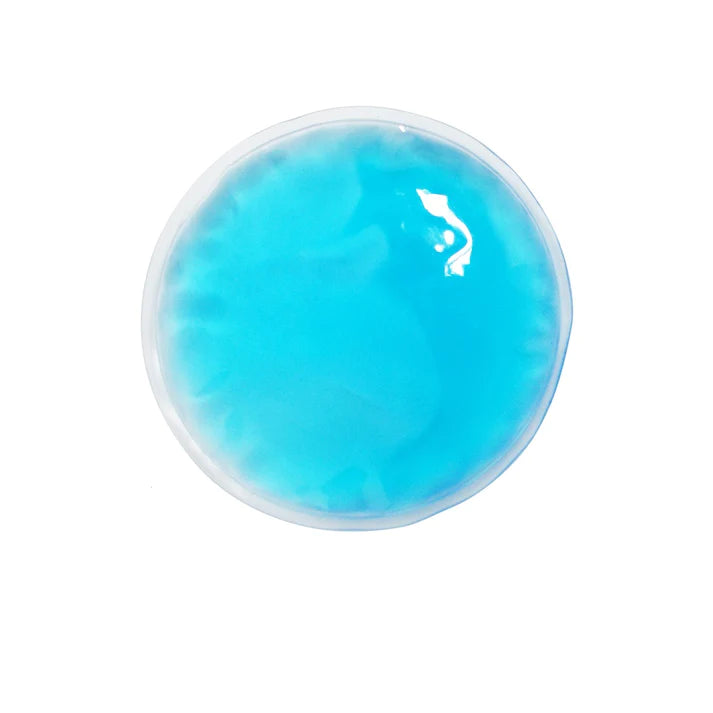
cadou surpriza

HEAR IT FROM THEM...
Rated 4.96/5 on 1.27k+ Happy Customers!
FAQs
Does the camera have built-in memory?
Does the camera have built-in memory?
The camera does not have built-in memory. It requires a memory card to store photos and videos. The package comes with Micro SD 16GB card. You are able to upgrade to 128gb.
What is the resolution of the camera's photos and videos?
What is the resolution of the camera's photos and videos?
The camera captures photos at up to 44 megapixels (44MP) resolution and records videos in Full HD 1080p resolution, ensuring high-quality images and footage.
Transfering photos to device
Transfering photos to device
To transfer photos from your digital camera to your phone, simply connect the camera to your phone using a USB cable or via Wi-Fi, depending on the camera's connectivity options.
Once connected, follow the prompts on your phone to access the camera's storage and select the photos you want to transfer. Then, choose the destination folder on your phone and confirm the transfer. Within moments, your nostalgic throwback memories will be safely stored on your phone, ready to be shared with friends and family on social media.
How to setup and snap
How to setup and snap
- Insert the rechargeable Li-Ion battery into the designated compartment in the camera.
- Close the battery compartment securely.
- Power on the camera by pressing the power button.
- Frame your shot using the viewfinder or LCD screen.
- Adjust settings such as zoom and focus using the control buttons.
- Press the shutter button halfway to focus, then fully to capture the photo.
- Review your photo on the LCD screen or viewfinder.
Shipping time and processing
Shipping time and processing
We offer a current flat rate - free worldwide shipping for all orders.
Order processing takes 1-3 days before shipment, depending on volume of orders. Once your item/s is dispatched, the estimated delivery time is:
- North America: (7-10 business days)
- Europe: (8-12 business days)
- Oceania: (6-10 business days)
- Rest of world: (8-15 business days)
Every customer is provided with tracking number directly after purchase!